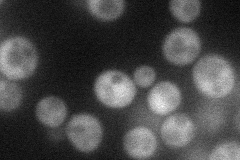
YER132C
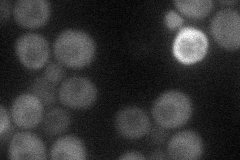
YER132C
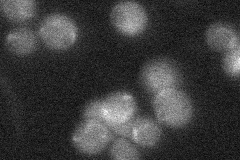
YER132C

View description
Protein with an N-terminal kelch-like domain, putative negative regulator of early meiotic gene expression; required, with Mds3p, for growth under alkaline conditions
Localization:
Intensity:
Fold change:
Significance:
-
C’ GFP library in SD

cytosol24.97 -
N' NOP1pr-GFP in SD
cytosol33.7366 -
N' TEF2pr-mCherry in SD
cytosol25.0606 -
N' NATIVEpr-GFP in SD
below threshold20.7267 -
N' TEF2pr-VC and Cyto-VN in SD

#N/A0 -
C’ GFP library in SD+DTT

cytosol26.791.07No -
C’ GFP library in SD+H2O2

cytosol30.141.2No -
C’ GFP library in Starvation Media

cytosol23.140.92No -
C’ GFP library on the background of Pup2-DaMP

cytosol -
C’ GFP library on the background of CCT mutant

cytosol24.73920.990527No
